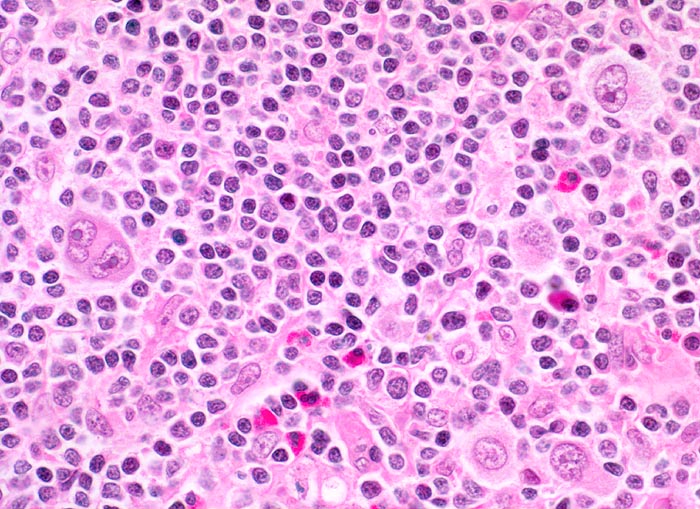

PathoPic – image database / PathoPic ID 3874 - Hodgkin-Lymphom, Mischzelltyp
de
Diagnose
Hodgkin-Lymphom, Mischzelltyp
Diagnose Gruppe
maligner Tumor
Topographie
Lymphknoten, Kopf-cervikal
Topographie Gruppe
Lymphatische Gewebe, KM, Milz
Beschreibung
Klinik
Vergrösserte zervikale und axilläre Lymphknoten, Fieber und Nachtschweiss.
Kommentar
Reed-Sternberg-Zellen sind grosse mehrkernige Zellen mit spiegelbildlich angeordneten Kernen und grossen eosinophilen Nukleolen. Sie entstehen aus Hodgkin-Zellen. Im Gegensatz zur nodulären Sklerose zeigen die neoplastischen Zellen beim Mischzelltyp keinen Retraktionsartefakt des Zytoplasma.
Bilder Typ
Histologie
Vergrösserung
400
Alter
28
Geschlecht
männlich
Datum
Ersteintrag: 01.07.2002
Update: 04.02.2024